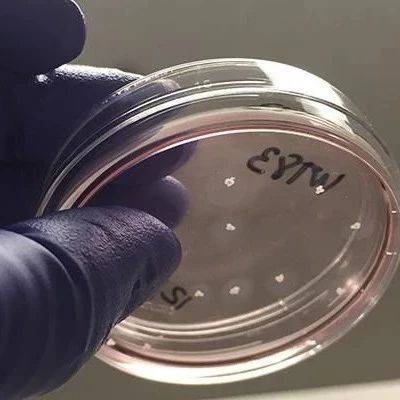

来源:新智元

人类大脑具有非凡的能力,可以在嘈杂的环境中挑选出特定的声音。比如,在嘈杂的酒吧里留意中意对象的说话、在车水马龙的街道分辨身后来车等等。
这在人类来说很轻松就能做到,可连最先进的助听器也无法实现。不过,哥伦比亚大学的工程师们正在改变这种情况。
他们宣布已经实现一项技术,可以模仿大脑天生具备的检测并放大特定声音的能力,并开发出一款由大脑控制的助听器。

助听器由AI驱动,可作为自动过滤器,监控佩戴者的脑电波并增强他们想要关注的声音,从而能够让佩戴者无缝并高效地与周围的人交流。
论文发表在Science Advances上。据悉,一作Cong Han在杭州科技大学获得学士学位,在哥伦比亚大学获得硕士学位。
鸡尾酒会难题哥伦比亚大学Mortimer B. Zuckerman Mind Brain Behavior Institute的主要研究员和该论文的资深作者Nima Mesgarani博士说,处理声音的大脑区域非常敏感,也非常强大,可以毫不费力的放大一个特定声音而不牵扯其他声音,今天的助听器却做不到。

那么通过创造一种利用大脑本能的助听设备,有望使全球数亿听障人士能够像普通人一样轻松地进行交流。
现代助听器在降噪方面已经做的非常出色了,但实现的过程却是通过提高特定种类的声音,使其盖过其它背景音。科学家称之为鸡尾酒会难题。
想象一下,我们在一个嘈杂的鸡尾酒会,不仅每个人都在说话,大厅还放着BGM。为了让身边的人听清楚你不得不提高嗓门说话,而旁边的人为了让你听清楚也不得不提高自己的音量。
哥伦比亚工程公司电气工程副教授Mesgarani博士说:“助听器会立刻放大所有人的声音,你仍然无法将你的谈话对象和其他人区分出来”
用脑电波来放大特定声音为什么会想到利用脑电波呢?Mesgarani称他们发现两个人在交谈的时候,讲者的脑电波开始和听着趋同。
于是该团队将语音分离算法与神经网络、以及模仿大脑自然计算能力的复杂数学模型相结合,开发了一款脑控助听器,使用脑电波来判断哪些声音应该被放大,哪些声音应该被抑制。
具体实现方式如下:
首先从一个组中分离出每个说话者的声音。设备自动将多个扬声器分离成单独的流,然后将每个扬声器与来自用户大脑的神经数据进行比对。一旦某人的声音模式与听者的脑电波匹配度最高,他的声音就会被放大。
其实团队早在2年前就发布了这项技术的初代版本,但限于预训练数据集,效果刚开始不是很理想。比如一旦出现不在数据集的声音,比如来个路人问路,系统就凌乱了。
好在哥伦比亚科技风险投资公司的资助下,团队对原始算法进行了改进,Mesgarani博士、第一作者Cong Han和James O'Sullivan博士再次利用深度神经网络,构建了一个更加复杂的模型,从而能够识别任何人声,从而解决了上述问题。

室内测试显示,效果还不错
为了测试该算法的有效性,研究人员与Northwell Health Institute for Neurology and Neurosurgery的神经外科医生Ashesh Dinesh Mehta合作,找来志愿患者听取不同的讲者发言,研究人员利用植入患者大脑的电极直接监测他们的脑电波、
当患者专注于一个扬声器时,系统会自动放大该声音。当他们的注意力转移到另一个扬声器时,音量水平发生变化以反映这种转变。
接下里,研究人员希望不用植入大脑这种太过简单粗暴的方式,例如将其置于头皮外部或耳朵周围。
目前为止只在室内环境中进行了测试,Mesgarani博士说未来有望在室外环境也实现相同的效果。
参考链接:
https://medium.com/predict/can-our-minds-live-forever-29105faf2d80
来源:AI_era 新智元
原文链接:http://mp.weixin.qq.com/s?__biz=MzI3MTA0MTk1MA==&mid=2652045698&idx=5&sn=4998cfbdf6dc2f92fd8d88a429c09237&chksm=f1207573c657fc65aa5dd2bb5f62f69baf12890d0f2918ec5887c304a1b943776ecb06eb7a0c&scene=27#wechat_redirect
版权声明:除非特别注明,本站所载内容来源于互联网、微信公众号等公开渠道,不代表本站观点,仅供参考、交流、公益传播之目的。转载的稿件版权归原作者或机构所有,如有侵权,请联系删除。
电话:(010)86409582
邮箱:kejie@scimall.org.cn